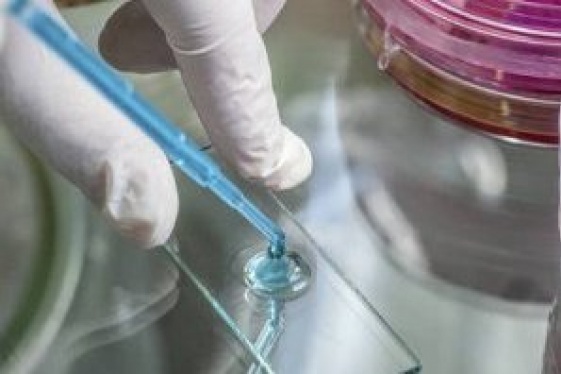

Nasce il tatuaggio hi-tech capace di leggere la salute del nostro corpo
di Maria Rosa Pavia La figlia di Francesco Greco, ricercatore all'Iit di Pontedera, aveva quattro anni e una vera passione per i tatuaggi temporanei, i «trasferelli» che rilasciano un'immagine sulla pelle bagnandoli con l'acqua. Greco in quel momento stava facendo una ricerca sui nano film polimerici e nella sua mente c'è stato un...
READ MOREItaly’s a surprising power in the robotics industry, in sixth place worldwide
by Luca Orlando Japan, Korea, but especially China. In geographic terms, these are the main buyers of robots in the global market, which has posted new records in terms of sales and stocks. Global orders for 2015 have, in fact, risen by 12%, reaching 250,000 units (double the figure of 2010), bringing the overall "mass" of installed indust...
READ MOREFiat Chrysler e Google insieme per l’auto che si guida da sola (a Mountain View)
Google Self-Driving Car Project e Fiat Chrysler automobiles hanno annunciato un'inedita collaborazione: Google amplierà il programma di sperimentazione di veicoli a guida autonoma con l'inclusione del nuovo minivan ibrido Chrysler Pacifica Hybrid e gli ingegneri di Fca US e gli ingegneri di Google lavoreranno insieme per integrare la tecnologia di...
READ MORETumori, scoperta una 'chiave' per bloccare cellule malate
SFRUTTANDO le conoscenze di base derivate dal sequenziamento del genoma umano, ricercatori di tutto il mondo stanno tentando di comprendere i meccanismi cellulari alla base di tante malattie, compresi quelli che portano al tumore. Si sta cercando di capire cioè il funzionamento di alcune molecole 'sospette', che potrebbero veicolare messaggi di mal...
READ MORELeonardo International Inc.
E' stata recentemente costituita sotto gli auspici del Consolato d'Italia a Detroit l'organizzazione non-profit 'Leonardo International Inc.' che avra' lo scopo di assistere i giovani italiani laureati in discipline scientifiche che desiderano intraprendere un'esperienza professionale internazionale e le PMI italiane impegnate in settori scientific...
READ MOREArchitetti: al via collaborazione Italia-Usa
Implementazione di accordi per lo sviluppo delle attività professionali; ricerca e sviluppo congiunti nello scambio di know-how nei settori della progettazione e della pianificazione, del project management e project financing; definizione e implementazione di progetti comuni sia negli Stati Uniti d'America sia in Italia per valorizzare la cooperaz...
READ MOREBiosphera 2.0: la casa del futuro installata ai piedi del Monte Bianco
di Carolina Saporiti "Una sera ero al Bivacco Amici della Montagna di Lagoscuro (sotto il Presana, in Trentino), che è un posto molto poco ospitale, e ho cominciato a pensare al progetto che poi sarebbe diventato Biosphera2.0" inizia così il racconto di Mirko Taglietti, CEO di Aktivhaus e "papà" di questa casa del futuro a energia zero, presentata...
READ MOREOttava conferenza dei ricercatori Italiani nel mondo (Houston, 1 dicembre 2012)
La Conferenza dei Ricercatori Italiani nel Mondo, organizzata dal COMITES con la collaborazione ed il patrocinio del Consolato Generale, si riunisce a Houston per la sua Ottava edizione. La Conferenza e' finalizzata alla presentazione e divulgazione del lavoro svolto dai ricercatori che sono collegati all'Italia grazie alla loro nazionalita' o sfer...
READ MOREScientists Say Coffee Is So Magical, It Can Even Undo Liver Damage
By Clint Rainey Keep it coming. Photo: Jose Luis Stephens/Masterfile/CorbisGreat news: The benefits of coffee are so plentiful that a new study has linkeddrinking two extra cups per day to a 44 percent drop in the risk of developing cirrhosis, an awful liver disease brought on by too much booze. Researchers at England's Southampto...
READ MORELED technology will help see The Last Supper under a new light
Leonardo Da Vinci's The Last Supper changes its lighting thanks to a new LED installation, guaranteeing energy savings and much lower heat emissions. This solution pollutes less and helps to better preserve Da Vinci's very delicate masterpiece, which can now only be visited in small groups. The new lighting system was prepared by Marche-based comp...
READ MORE